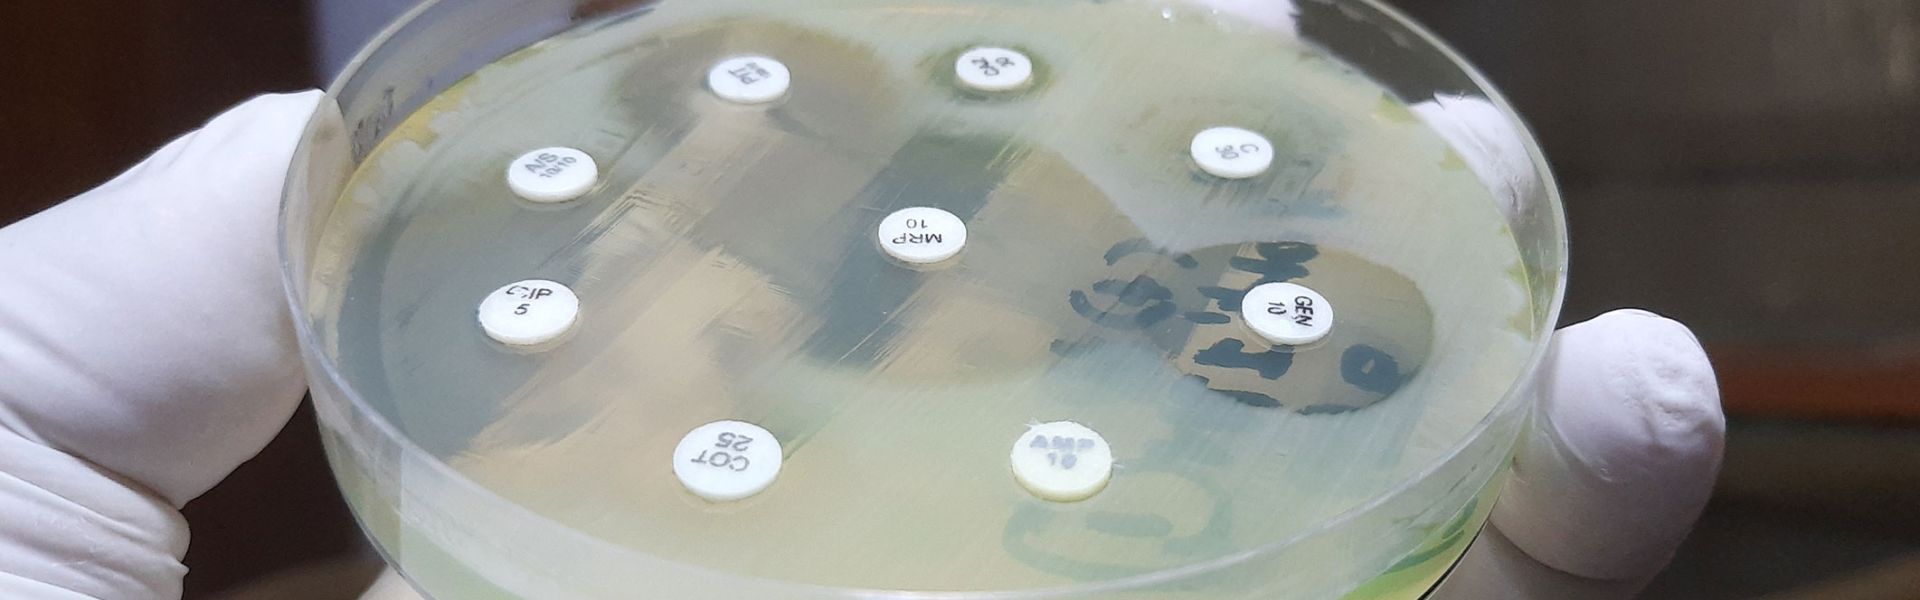

Antimicrobial resistance in animals: bacterium/antibiotic combinations for priority monitoring
Continue reducing the use of veterinary antibiotics
Between 2011 and 2021, overall animal exposure to antibiotics fell by 47%. This trend reflects the efforts by farmers and the veterinary profession to reduce their use, encouraged by the public authorities under the two successive EcoAntibio plans.
In human medicine, for several years now France has ranked fourth among European countries in terms of antibiotic consumption, 90% of which is prescribed and dispensed in the primary care sector. For this reason, continuing to reduce the use of antibiotics in both human and animal health must remain a priority in the strategy to prevent antimicrobial resistance and, with it, infections.
Five bacterium/antibiotic class combinations classified as high priority
As part of its expert appraisal, ANSES drew up, for the very first time, a French list of bacterium/antibiotic class combinations requiring priority monitoring in animals because of their major importance to human health. This list is based on three health criteria: the transmissibility of antimicrobial resistance, the possibility of using alternative antibiotics, and the number of infections and deaths attributable to them.
Of the 11 combinations on this list, five are classified as high priority:
- Enterobacterales/carbapenems;
- Enterobacterales/third- and fourth-generation cephalosporins;
- Staphylococcus aureus/methicillin;
- Enterobacterales/fluoroquinolones;
- Enterobacterales/polymyxins.
If a bacterium resistant to an antibiotic class on this high-priority list is detected in a livestock animal or pet while it is being treated, the Agency recommends sequencing to determine the bacterium's entire genome. The aim is to assess and quantify the degree to which the animal reservoir contributes to the transmission of these resistant bacteria to humans.
Pay attention to imported food and animals
In France, the transmission of bacterial resistance between animals and humans is controlled by biosecurity measures on farms, compliance with good hygiene practices in veterinary clinics, and the cooking of food.
However, increased global trade can enable antibiotic-resistant pathogens to be disseminated very quickly. The Agency is therefore calling for the monitoring of antibiotic-resistant bacteria in foodstuffs to be broadened to include aquaculture products and live farm animals from countries outside the European Union. Such imports could encourage the introduction into France of bacteria carrying new resistance genes, or even multi-resistant bacteria. The latter pose a major threat to public health because they can lead to therapeutic dead-ends.
Take account of local situations and encourage a participative, multi-stakeholder approach
Developing and implementing measures to manage antimicrobial resistance require a collective, participative and systemic approach. The Agency stresses the need for coordinated and early involvement of all stakeholders – farmers, veterinarians, technicians, slaughterhouse professionals, epidemiologists, animal owners, etc. – in the process of designing these measures. They should also be tailored to the contexts in which they will be applied. Lastly, the links between the human and animal health sectors need to be strengthened.


